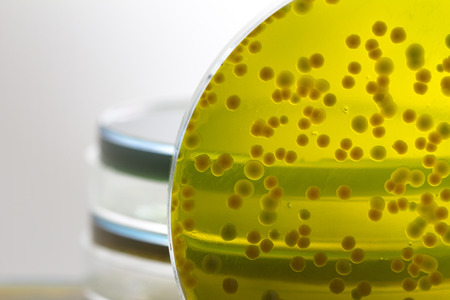
Closeup for plate Bacteria culture growth on Selective media in Microbiology room at Laboratory, vibrio sppの写真素材

写真素材 - Closeup for plate Bacteria culture growth on Selective media in Microbiology room at Laboratory, vibrio spp
作品情報
Closeup for plate Bacteria culture growth on Selective media in Microbiology room at Laboratory, vibrio spp
- ID:95977276
- 作品種別:写真
- 作者名:Somprasong Wittayanupakorn
キーワード
- abstract
- agar
- arius
- background
- bacteria
- bacterial
- bacterium
- biology
- biotechnology
- black
- blood
- care
- cell
- colonies
- colony
- color
- culture
- danger
- differential
- dish
- growth
- health
- isolated
- lab
- laboratory
- media
- medical
- medicine
- medium
- micro
- microbe
- microbiology
- pathogen
- pet
- petri
- plate
- red
- research
- ri
- safety
- salmonella
- science
- scientific
- selective
- shigella
- species
- streak
- test
- white
- yellow
類似作品
Backgrounds of ...
Colony of blue ...
Macro close up ...
Close up of bac...
Diverse colorfu...
Melon skin text...
Close-up of bac...
Close up of col...
close-up of sci...
Close-up of ger...
bacteria colony...
Mold Beautiful,...
close-up of bac...
close-up of col...
Colorful variet...
Surface contami...
petri dish with...
detail of bacte...
Laboratory petr...
Cells that caus...
Colony characte...
Macro close up ...
macro of bacter...
Bacteria on a w...
Probiotics bact...
Dynamic motion ...
Colonies of dif...
Colorful bacter...
Bacteria. Bacte...
Microscopic Vie...
Backgrounds of ...
Ascariasis is a...
colony of becte...
Scientific imag...
bacteria colony...
Surface with ba...
This vivid abst...
Threads of fung...
Oil texture. Vi...
melon fruit tex...
Enterobacterias...
Escherichia col...
Visualization o...
microbial cultu...
petri dish with...
microbial cultu...